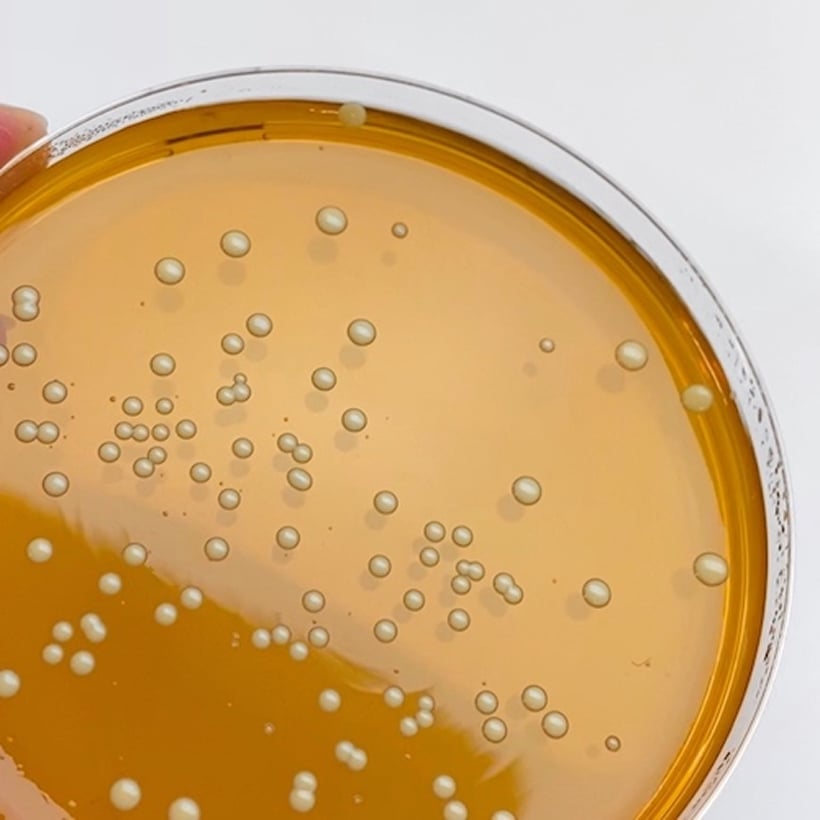
Szalka Petriego z koloniami bakterii w laboratorium.

Nasz zespół badawczy zidentyfikował odpowiednie szczepy bakterii, które są wystarczająco silne, aby zwalczać szkodliwe bakterie i grzyby, nie naruszając przy tym naturalnej równowagi mikrobiomu skóry. Dzięki temu odkryciu naukowemu pielęgnacja skóry z użyciem dobroczynnych bakterii stała się wreszcie możliwa!
SELEKCJA ODPOWIEDNICH SZCZEPÓW BAKTERII
Znacząca część mikrobiomu skóry kształtuje się już w pierwszych dniach po urodzeniu. Mikrobiom ten składa się z licznych korzystnych bakterii, które chronią noworodka przed szkodliwymi czynnikami zewnętrznymi w pierwszych miesiącach życia. Bazując na tej wiedzy, zadaliśmy sobie pytanie: czy można wykorzystać te same szczepy bakterii, które naturalnie kolonizują skórę noworodków, jako rozwiązanie współczesnych problemów skórnych?
„Te żywe bakterie kwasu mlekowego, które chronią skórę noworodków, mają pozytywny wpływ na mikrobiom skóry. Wybraliśmy te konkretne szczepy probiotyczne w badaniach przedklinicznych ze względu na ich bezpieczeństwo, możliwość aplikacji i aktywność biologiczną.”
— Dr Ingmar Claes, Dyrektor Naukowy YUN
W oparciu o naszą wewnętrzną wiedzę z zakresu probiotyków, przeprowadziliśmy racjonalną selekcję in vitro, w której wyłoniliśmy trzy szczepy probiotyczne o wysokiej skuteczności w pielęgnacji skóry skłonnej do trądziku:
Lactobacillus rhamnosus YUN-S1.0,
Lactobacillus pentosus YUN-V1.0,
Lactobacillus plantarum YUN-V2.0.
CZYM JEST „LACTOBACILLUS”?
Lactobacillus to pałeczkowata bakteria, odgrywająca istotną rolę zarówno w organizmie człowieka, jak i zwierząt. Występuje m.in. w przewodzie pokarmowym oraz w żeńskim układzie płciowym. Lactobacillus chroni organizm przed inwazją niekorzystnych bakterii, a my – jako gospodarze – dostarczamy tym bakteriom substancji odżywczych. Czerpią one energię z fermentacji laktozy, glukozy oraz innych cukrów. W wyniku tego procesu powstaje kwas mlekowy (łac. lacto = mleko), który zakwasza środowisko, utrudniając rozwój niekorzystnych bakterii.